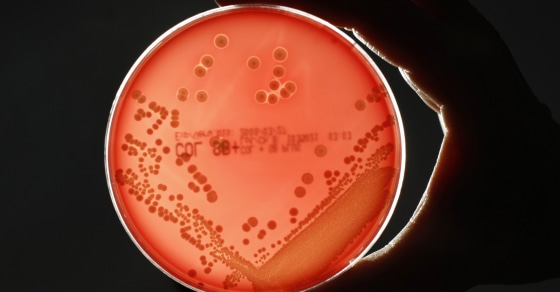
Image: MRSA bacteria are seen in a petri dish in a microbiological laboratory in Berlin

Nearly twice as many people are dying from drug-resistant infections in the United States than previously thought, according to a report published Wednesday by the Centers for Disease Control and Prevention.
"Superbugs" are responsible for more than 35,000 deaths and nearly 3 million illnesses each year, the report found.
The increase in deaths comes as researchers develop more sophisticated techniques to identify the deadly infections.
"Our first number was a conservative estimate," Michael Craig, senior adviser for antibiotic resistance at the CDC, said. "We have more concrete evidence that these infections actually lead to their deaths."

Superbugs evolve when the germs — including bacteria and fungi — become resistant to nearly all of the medications used to fight them. The fear, experts say, is that patients will develop once-treatable infections that are now resistant to every possible treatment.
"This is not some mystical apocalypse or fear-mongering. It is reality," said Dr. Victoria Fraser, the head of the Department of Medicine at the Washington University School of Medicine in St. Louis.
"It’s right here, right now," she said. "We are faced with trying to take care of patients who have drug-resistant infections that we have no treatment for." Fraser was not involved with the new CDC report.
Some of the most common drug-resistant illnesses are urinary tract infections, particularly among women and the elderly, as well as hospitalized patients who need urinary catheters.
When doctors place catheters or other devices, such as IVs, pacemakers and artificial joints, inside the body, the risk for infection rises. It's these infections that are increasingly difficult to control and treat.
"A lot of the things that we’ve come to rely upon to prolong life in our country are really predicated on being able to use and have an effective antibiotic in case someone gets an infection," Craig said.
"We don’t want to be in a position where people are surviving their cancer treatments because of great chemotherapy drugs but then ultimately dying of a drug-resistant infection because we don’t have an effective antibiotic," he told NBC News.
People most vulnerable to drug-resistant infections are often very sick already and have compromised immune systems. Young children and the elderly are most at risk, too, but some of the superbugs are affecting otherwise healthy people.
"Some of these infections are now affecting healthier populations, which is a growing concern for us," Caig said.
Five urgent threats
The report highlights five types of drug-resistant organisms the CDC deems "urgent threats."
One is a type of yeast, called Candida auris, which causes fungal infections. Another is the bacterium Neisseria gonorrhoeae, the cause of gonorrhea.
Two groups of bacteria are also on the list: Acinetobacter, which is commonly found in soil and water and can cause infections in blood, the urinary tract, and the lungs, or in open wounds; and carbapenem-resistant Enterobacteriaceae, or CRE. This group includes E. coli and Klebsiella pneumoniae.
The last is Clostridioides difficile, commonly called C. diff. Though these bacteria aren't as drug-resistant as the other organisms listed, the infection can cause deadly diarrhea. When researchers included deaths associated with C. diff in the report, yearly superbug deaths in the U.S. rose by 13,000, to 48,000 deaths.
Fighting the problem
One way to fight drug-resistant infections is by developing new drugs to which the superbugs haven't yet evolved resistance. But this leads to what experts call an evolutionary arms race, with scientists and superbugs constantly one-upping each other.
The responsibility doesn't only lie in scientists' hands, however. "We all have to do more," Craig said. "If everyone steps up, we know prevention is possible and we can see change."
There are a number of ways people can help combat the superbug problem and prevent it from getting worse. It starts with avoiding illnesses before antibiotics or anti-fungals are ever needed.
First, get the appropriate vaccines. Pneumococcal vaccine protects against bacterial pneumonia. And if you get the flu shot, you not only cut your risk of flu, but also secondary bacterial complications that can accompany severe cases.
Practice good hand hygiene, meaning washing your hands with soap multiple times a day: before and after preparing food, before and after treating wounds and cuts, after going to the bathroom, after caring for sick children or changing diapers, and after cleaning up your pet's poop.
Take antibiotics only when necessary, exactly as the doctor prescribes them. "Using antibiotics when they’re not indicated or when they’re used for too long or at inadequate doses alters people’s microbiome," Fraser said, referring to the collection of microbes that live in the gut.
Antibiotics kill off bad bacteria, but also good, healthy bacteria in the gut and on the skin. Upsetting this delicate balance can put you at risk for diarrhea and yeast infections.
Practice safe sex. When used consistently and correctly, condoms can greatly reduce the risk of getting a sexually transmitted infection, such as drug-resistant gonorrhea.
When possible, choose meats from animals raised without unnecessary antibiotics. Just like in humans, overuse of antibiotics in farm animals can also lead to drug resistance. Those resistant germs can contaminate meat when the animals are slaughtered and processed.
Follow NBC HEALTH on Twitter & Facebook.